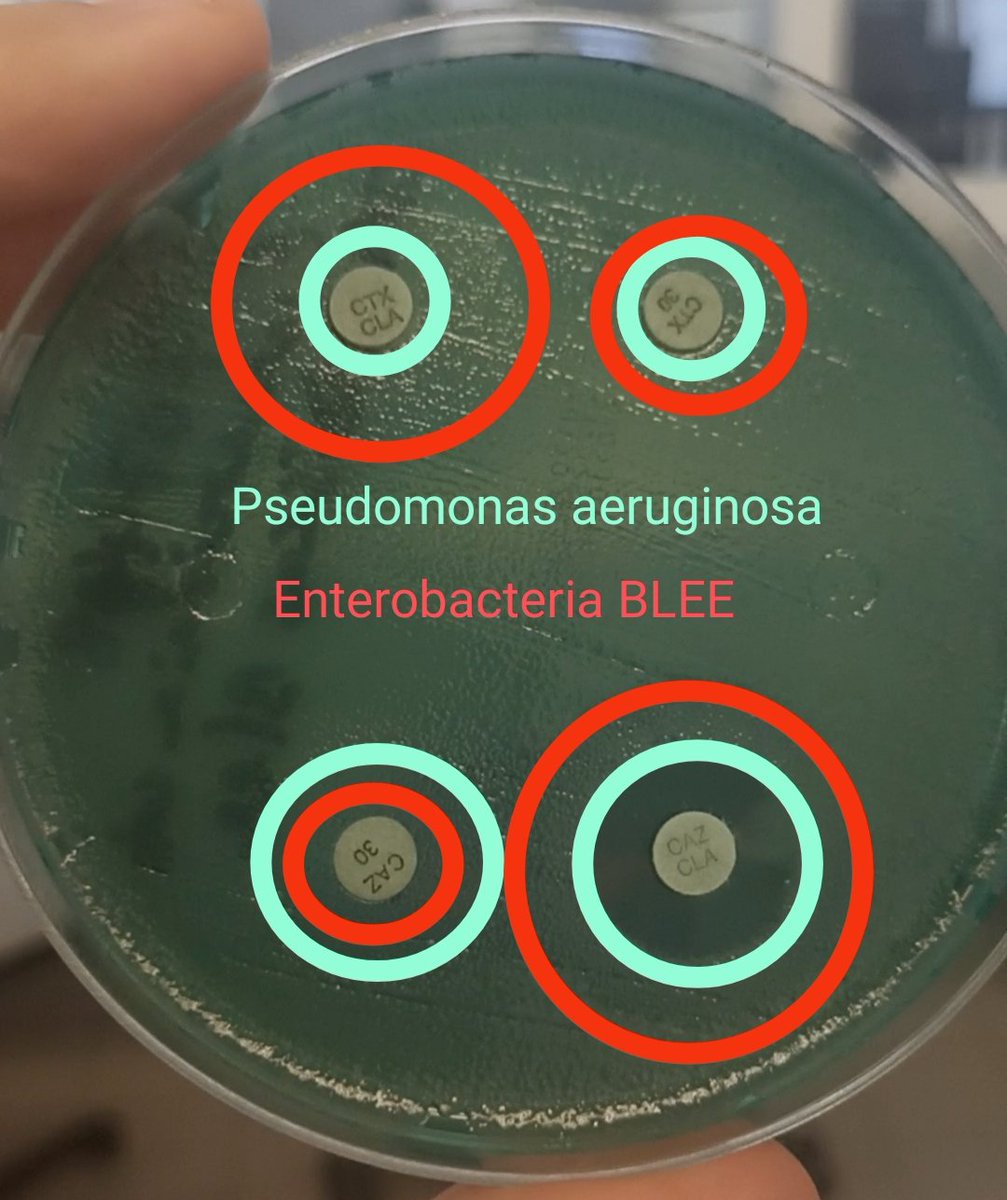
Ander González-Sarría tweet media
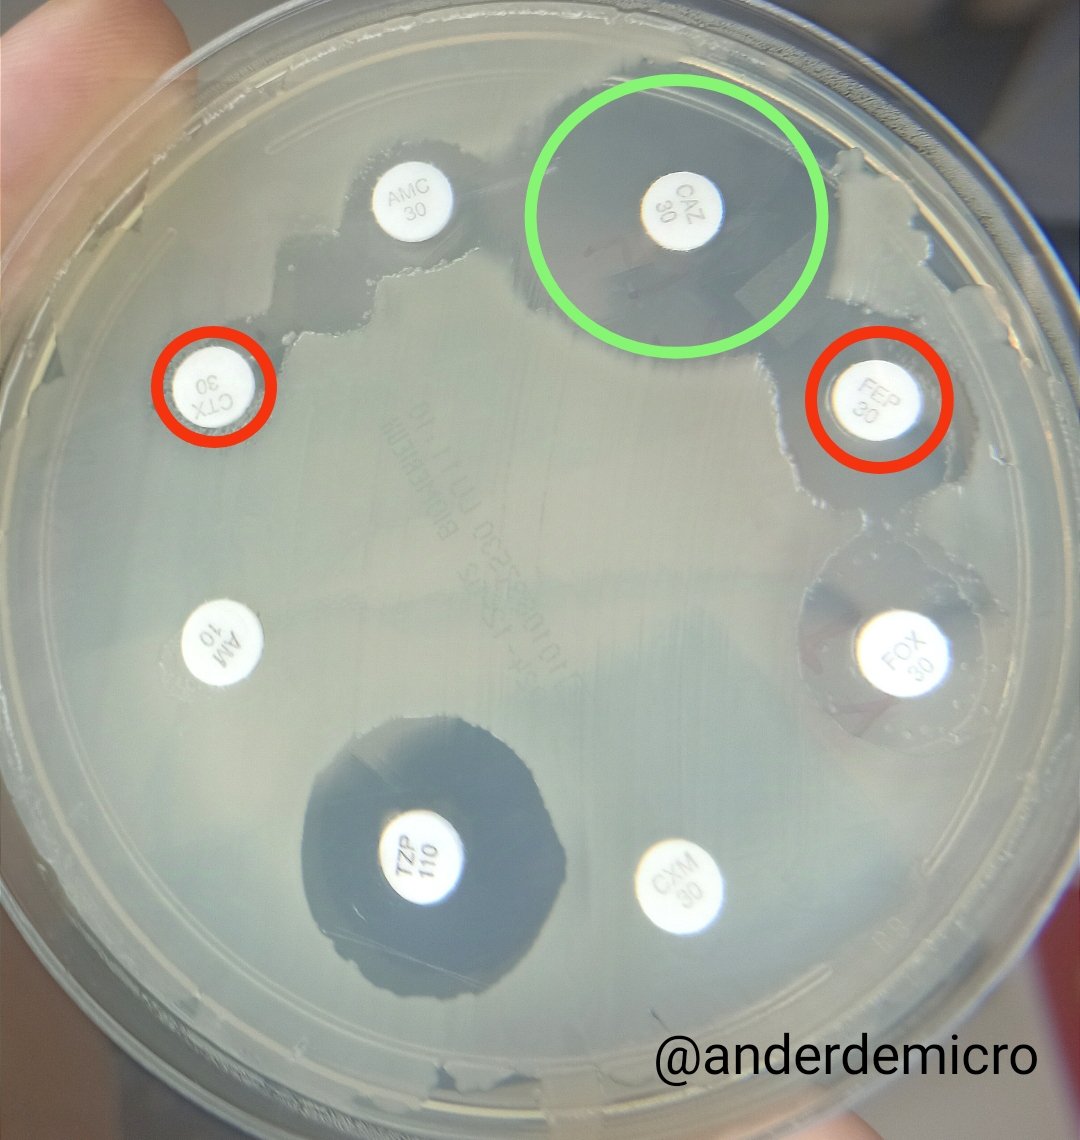
Ander González-Sarría tweet media
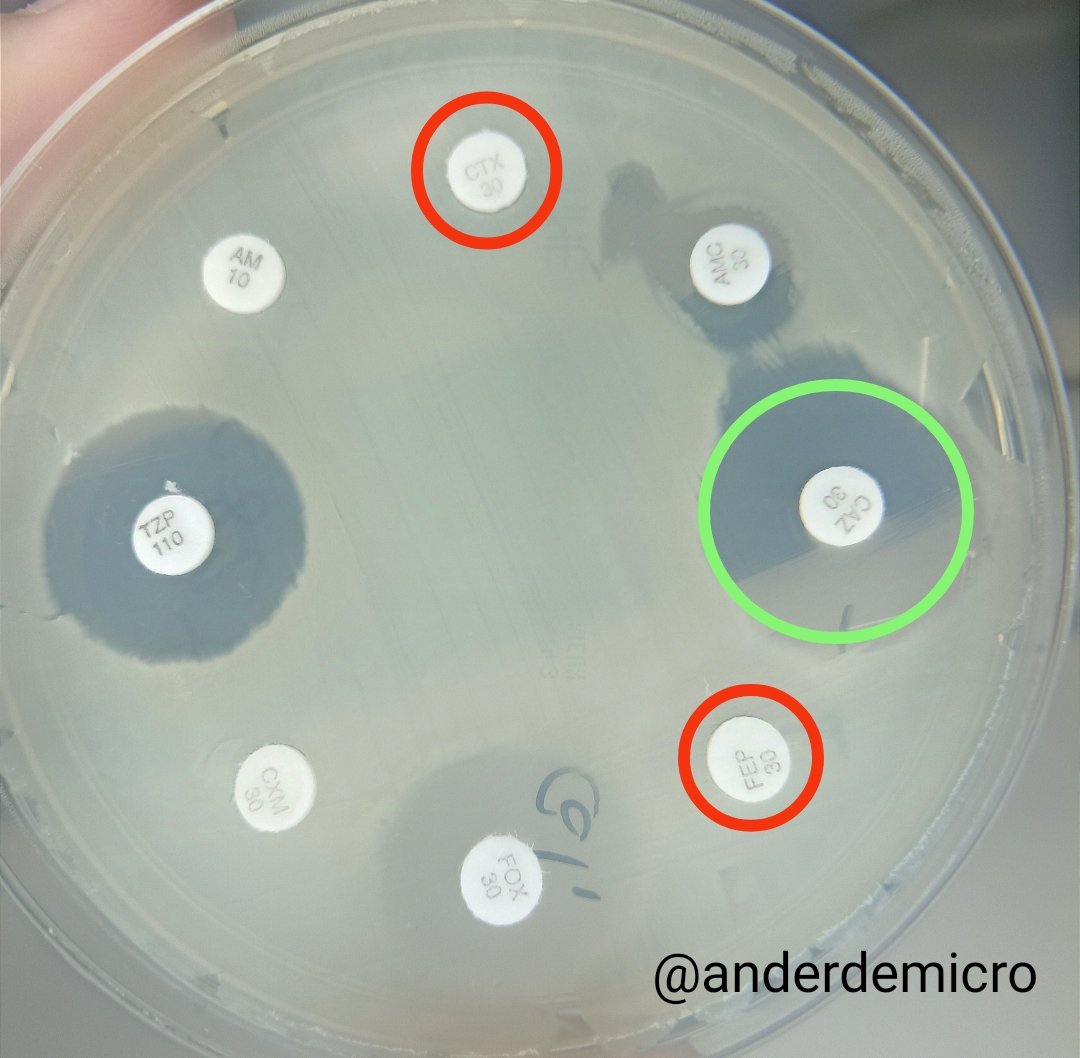
Ander González-Sarría tweet media

Ander González-Sarría retweetledi

🎙️ Nuevo episodio del podcast: analizamos el aumento de las ITS, resistencias, cribado en migrantes y viajeros, chemsex, PrEP y los retos actuales en consulta con @anderdemicro. No os lo perdáis.
Escúchalo aquí 👉open.spotify.com/episode/09CWcp…
Español